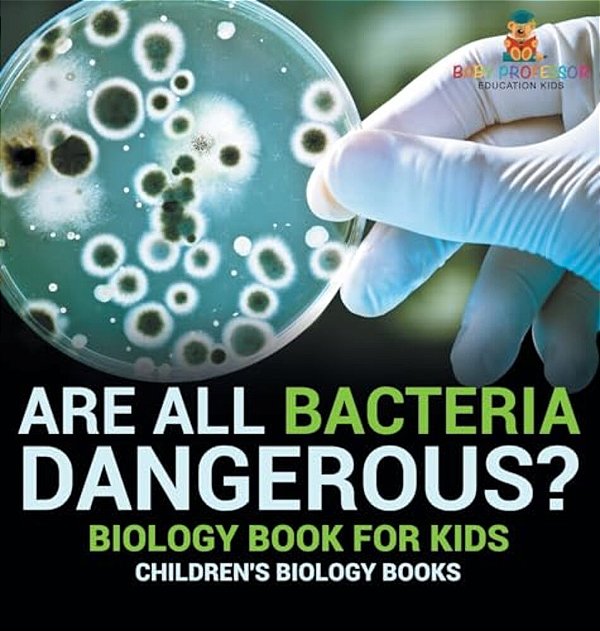
Are All Bacteria Dangerous? Biology Book For Kids Children's Biology Books-..

Are All Bacteria Dangerous? Biology Book For Kids Children's Biology Books-..
-
- 1x de R$ 282,12 sem juros
- 2x de R$ 141,06 sem juros
- 3x de R$ 94,04 sem juros
- 4x de R$ 70,53 sem juros
-
R$ 268,01

-
R$ 282,12

If you're child is into science or you would like him/her to be then this biology book is a must-have! Bacteria is always all around us but that doesn't mean we should be perpetually afraid of them. Lack of knowledge on the subject will make you fear too much. That is why it is important to encourage your child to pick up the habit of r
Produtos relacionados
-
 Are All Bacteria Dangerous? Biology Book For Kids Children's Biology Books-..R$ 149,32até 2x de R$ 74,66 sem jurosou R$ 141,85 via Pix
Are All Bacteria Dangerous? Biology Book For Kids Children's Biology Books-..R$ 149,32até 2x de R$ 74,66 sem jurosou R$ 141,85 via Pix -
 Are All Bacteria Dangerous? Biology Book For Kids Children's Biology Books-..R$ 182,52até 3x de R$ 60,84 sem jurosou R$ 173,39 via Pix
Are All Bacteria Dangerous? Biology Book For Kids Children's Biology Books-..R$ 182,52até 3x de R$ 60,84 sem jurosou R$ 173,39 via Pix -
 Virus Vs. Bacteria: Knowing The Difference - Biology 6Th Grade Children's Biology Books-..R$ 282,12até 4x de R$ 70,53 sem jurosou R$ 268,01 via Pix
Virus Vs. Bacteria: Knowing The Difference - Biology 6Th Grade Children's Biology Books-..R$ 282,12até 4x de R$ 70,53 sem jurosou R$ 268,01 via Pix -
 Virus Vs. Bacteria Knowing The Difference - Biology 6Th Grade Children's Biology Books-..R$ 149,32até 2x de R$ 74,66 sem jurosou R$ 141,85 via Pix
Virus Vs. Bacteria Knowing The Difference - Biology 6Th Grade Children's Biology Books-..R$ 149,32até 2x de R$ 74,66 sem jurosou R$ 141,85 via Pix
-
Categorias
Conteúdo
Sobre a loja
Myre Livraria, sua livraria online especializada em importação e revenda de livros nacionais e internacionais. Oferecemos uma vasta seleção de materiais didáticos de alta qualidade para aprender inglês, espanhol, francês, alemão e muito mais. Aproveite preços competitivos e entrega rápida em todo o Brasil
Pague com
Selos